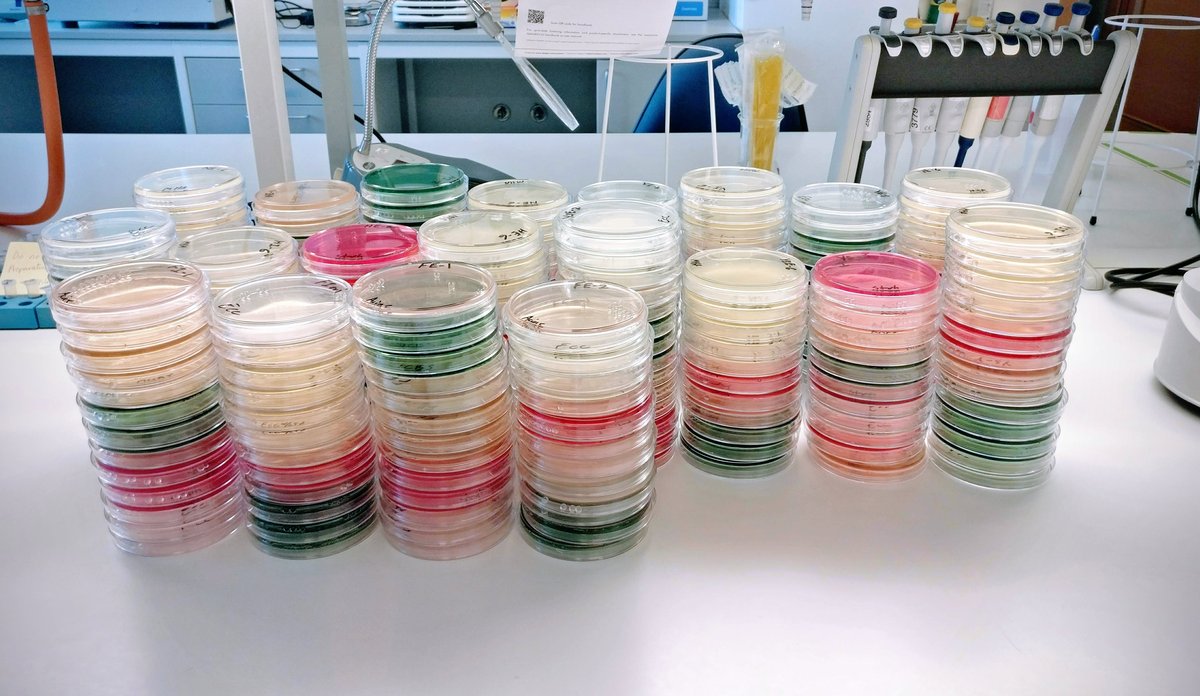
Foto av petriskåler med bakterieprøver
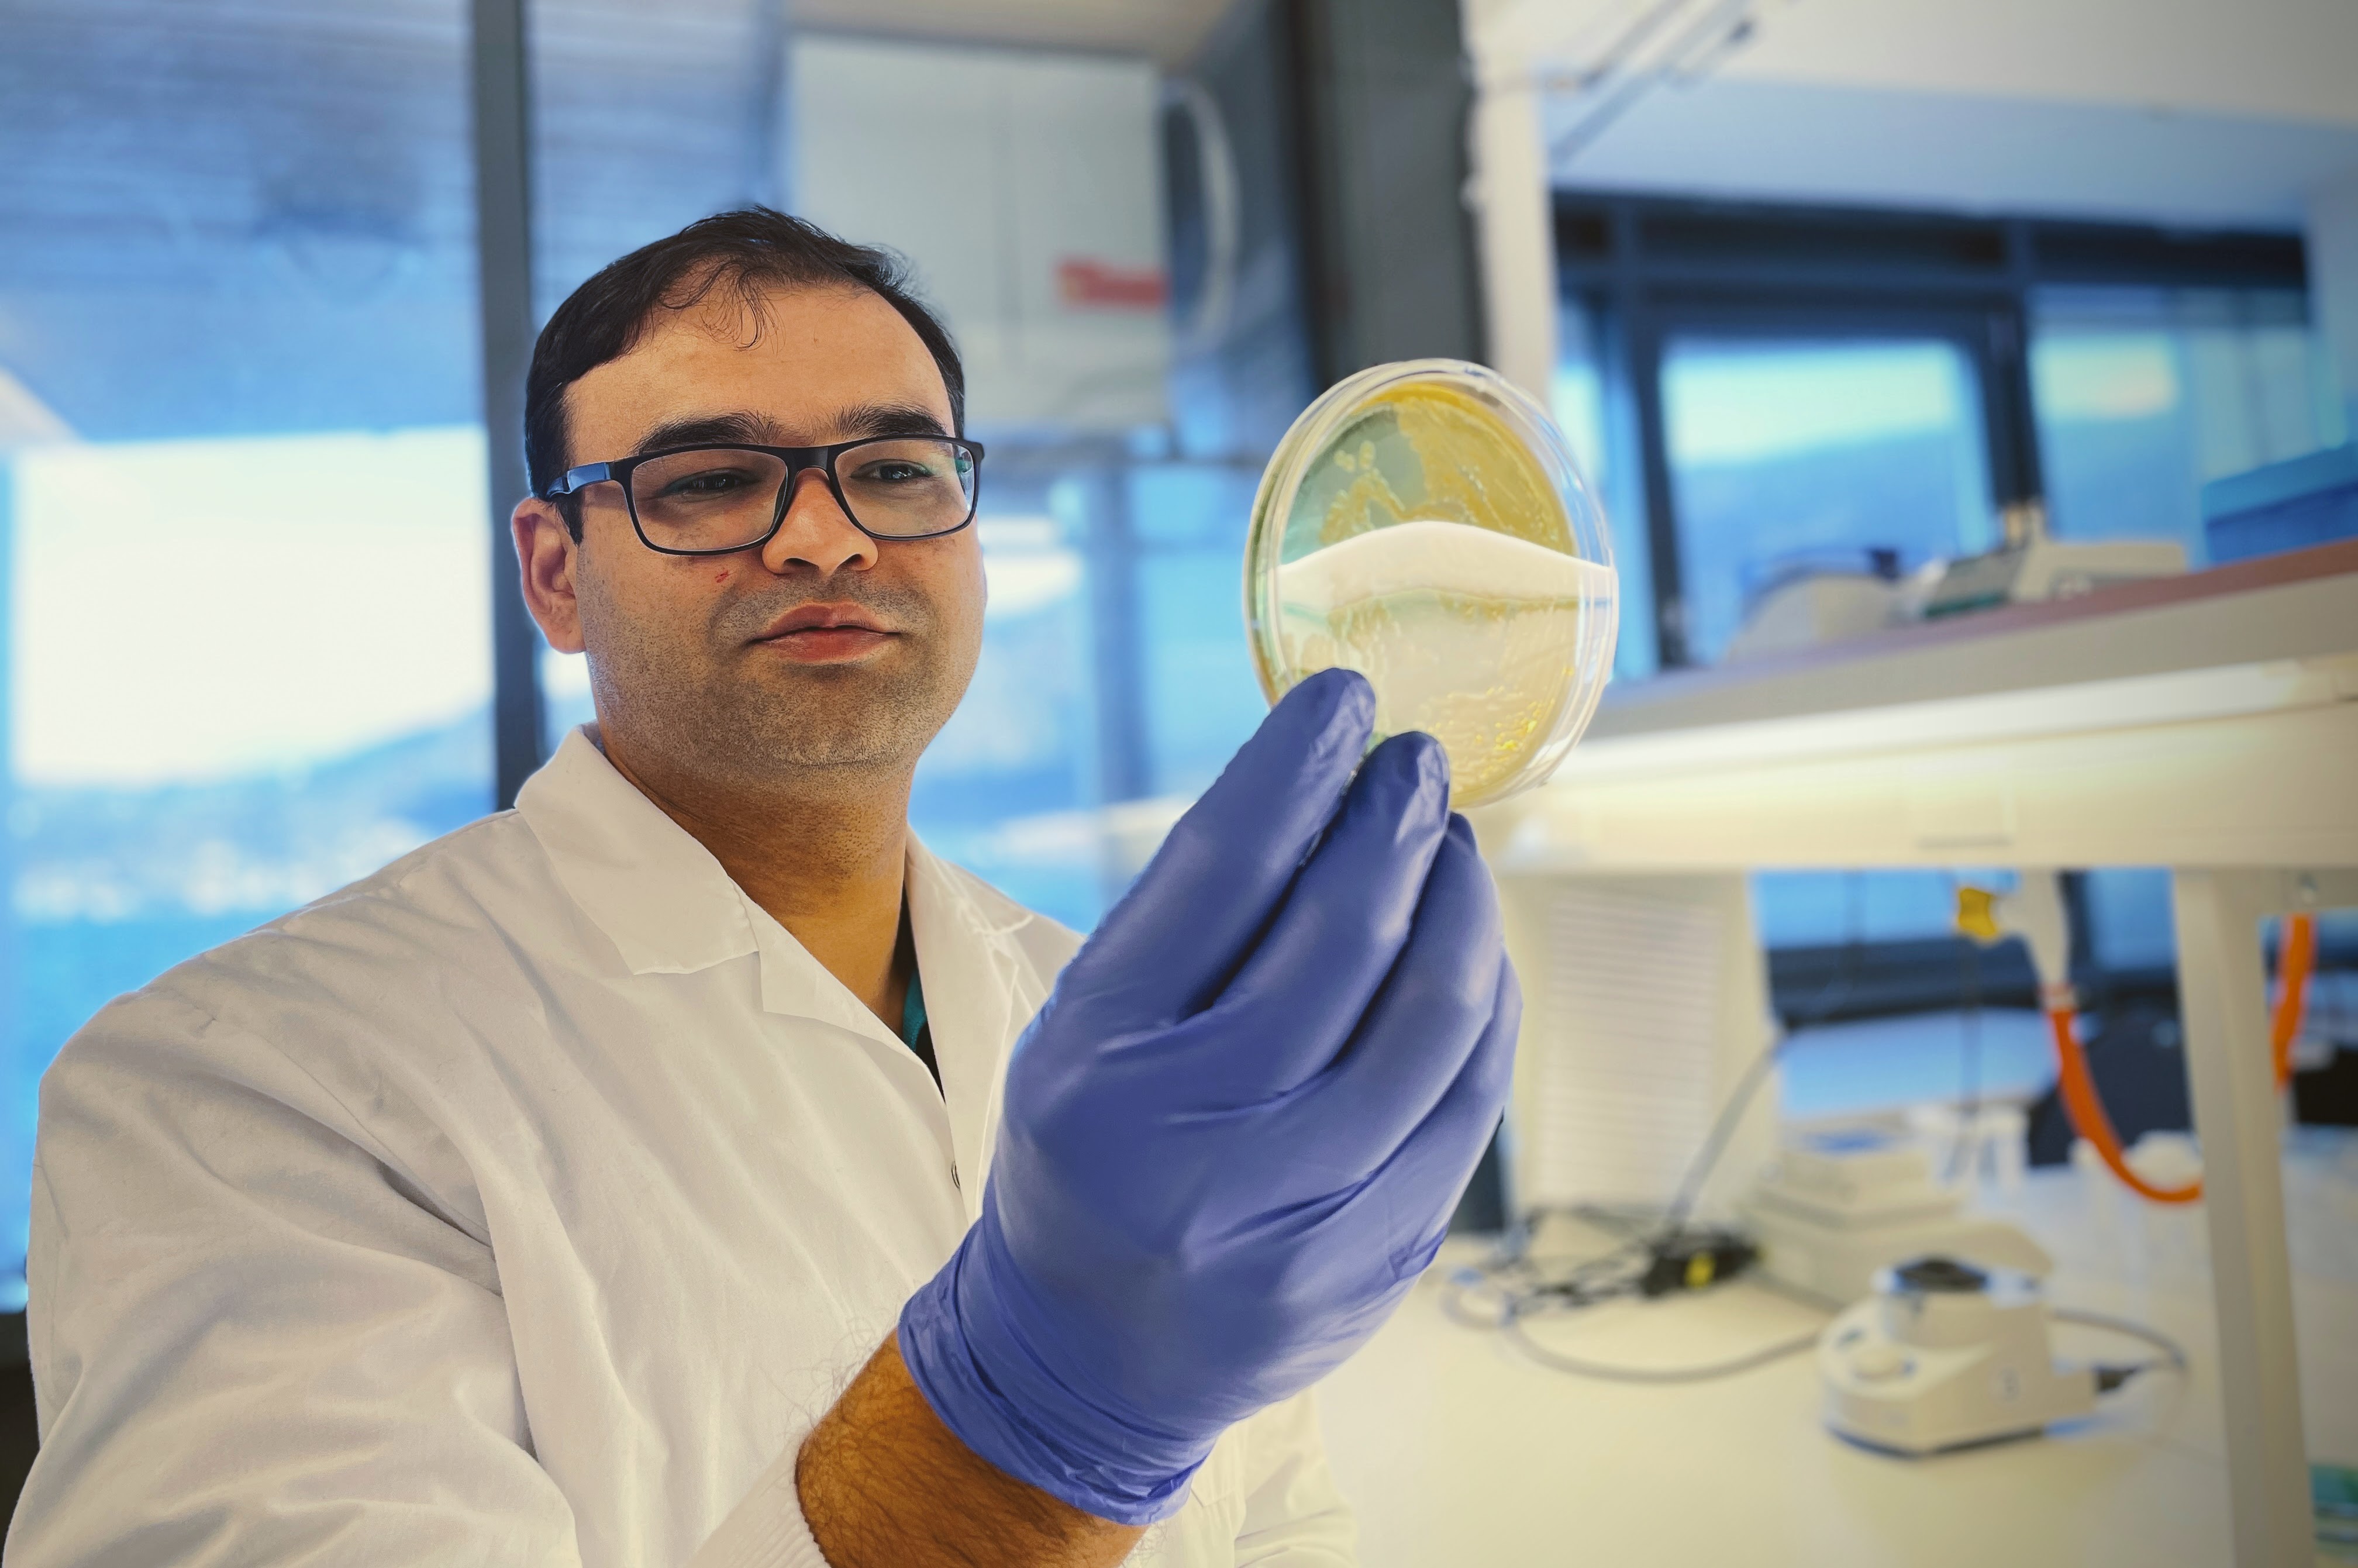
foto av professor som ser i petriskål

Fant resistens mot viktig antibiotika hos vanlig bakterie
Petriskåler med prøver av den isolerte bakterien som de hadde hentet fra makrellens innvoller.
Fotograf: Nachiket Marathe / HIPublisert: 06.02.2023 Oppdatert: 20.02.2023
Bakterier som er resistente mot antibiotika er et alvorlig og økende problem i hele verden. I 2019 døde omtrent 1,3 millioner mennesker som følge av slike bakterier.
I havet finnes det naturlig mange bakterier, samt bakterier som tilføres fra land. Noen av disse bakteriene har gener som gjør dem motstandsdyktige mot visse typer antibiotika.
I en ny studie har forskere for første gang oppdaget et nytt plasmid hos bakterien Shewanella baltica som bærer gener for resistens mot det viktige antibiotikumet colistin. Et plasmid er et genetisk element som kan overføres mellom bakterier.
Bakterien Shewanella baltica er en vanlig bakterie som kan ødelegge og forringe kvaliteten på mat.
– Colistin er det vi kaller for «siste utvei»-antibiotika. Det vil si at det er denne som brukes når andre antibiotika ikke virker, sier forsker og prosjektleder Nachiket Marathe.
Bakterie som ødelegger mat
Bakterien Shewanella baltica er utbredt i det marine miljøet og finnes også hos fisk.
Bakterien kan vokse ved kalde temperaturer, og er en vanlig bakterie som kan ødelegge mat, for eksempel kjølelagrede sjømatprodukter av laks og reker. – I denne studien har vi påvist at en vanlig matbakterie som finnes i fisk kan bære og spre antibiotikaresistens mot et viktig antibiotikum som colistin, sier Marathe.
14 av 33 hadde resistensgener mot colistin
I studien analyserte forskerne 33 ulike Shewanella-bakterier fra atlantisk makrell. De fant at 14 av de 33 bakterieisolatene hadde et gen som gir resistent mot colistin.
Genanalyser viste også at shewanella-bakterien bar dette genet, kalt mcr4.3, på et nytt plasmid.
– Dette gjør at de resistente genene kan spre seg fra bakterie til bakterie. Samtidig utgjør det også en risiko for overføring av slike resistensgener til bakterier som finnes i mennesker via sjømaten, sier Marathe.
Resistent mot tungmetaller
Forskerne oppdaget at det samme plasmidet også hadde gener som gir resistens mot tungmetaller som kobber, sink, arsen og kvikksølv.
Disse tungmetallene brukes for eksempel på skipsskrog og akvakulturnett for å hindre vekst av alger, skjell og sekkedyr.
Eksponering for tungmetaller, som kobber, har vist å kunne gjøre bakteriene mer resistent mot antibiotika.
– Bakteriene som er resistent mot disse tungmetallene vil også kunne trives og vokse i disse miljøene, sier Nachiket.
Nachiket og kollegene hans følger nøye med på hvilken rolle havet spiller i utviklingen og spredningen av antibiotikaresistens.
